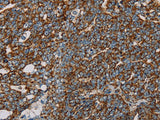
NDUFS3 Polyclonal Antibody Store at -20°C

NDUFS3 Polyclonal Antibody Store at -20°C
SKU: E-AB-11431-200
NDUFS3 Polyclonal Antibody Store at -20°C
| SKU # | E-AB-11431 |
| Reactivity | Human, Mouse |
| Host | Rabbit |
| Applications | WB, IHC |
Product Details
| Isotype | IgG |
| Host | Rabbit |
| Reactivity | Human, Mouse |
| Applications | WB, IHC |
| Clonality | Polyclonal |
| Immunogen | Recombinant protein of human NDUFS3 |
| Abbre | NDUFS3 |
| Synonyms | 30-KD SUBUNIT, CI 30, CI 30KD, CI-30kD, COMPLEX I, Complex I 30KD, Complex I 30kDa subunit, Complex I-30kD, MITOCHONDRIAL RESPIRATORY CHAIN, NADH coenzyme Q reductase, NADH dehydrogenase (ubiquinone) Fe S protein 3 30kDa, NADH dehydrogenase [ubiquinone, mitochondrial |
| Swissprot | |
| Calculated MW | 30 kDa |
| Cellular Localization | Mitochondrion inner membrane. |
| Concentration | 0.2 mg/mL |
| Buffer | Phosphate buffered solution, pH 7.4, containing 0.05% stabilizer and 50% glycerol. |
| Purification Method | Affinity purification |
| Research Areas | Cancer, Cell Biology, Metabolism, Signal Transduction |
| Conjugation | Unconjugated |
| Storage | Store at -20°C Valid for 12 months. Avoid freeze / thaw cycles. |
| Shipping | The product is shipped with ice pack,upon receipt,store it immediately at the temperature recommended. |
Related Reagents
| Applications | Recommended Dilution |
| WB | 1:500-1:2000 |
| IHC | 1:50-1:200 |
Background
This gene encodes one of the iron-sulfur protein (IP) components of mitochondrial NADH:ubiquinone oxidoreductase (complex I). Mutations in this gene are associated with Leigh syndrome resulting from mitochondrial complex I deficiency.